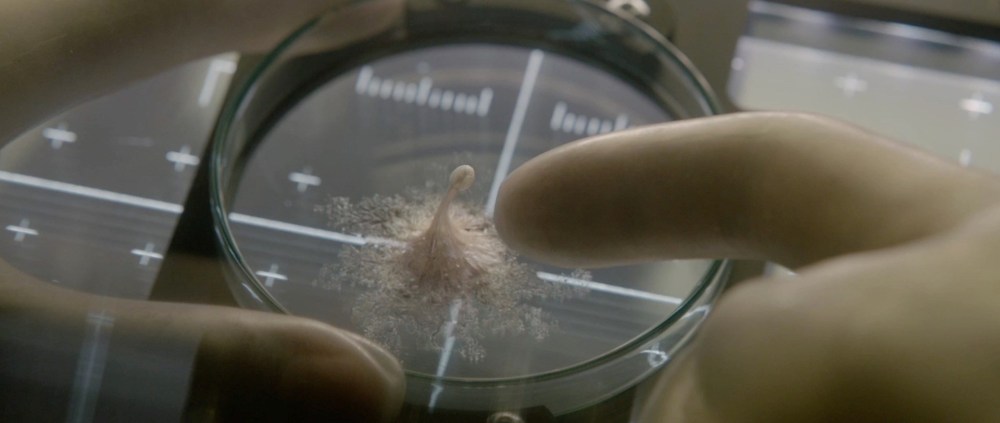

Time: 123 Minutes
Age Rating:
Contains violence, horror scenes & offensive language
Cast:
Jake Gyllenhaal as David Jordan
Rebecca Ferguson as Miranda North
Ryan Reynolds as Rory “Roy” Adams
Hiroyuki Sanada as Sho Murakami
Ariyon Bakare as Hugh Derry
Olga Dihovichnaya as Katerina Golovkina
Director: Daniel Espinosa
Astronauts (Jake Gyllenhaal, Rebecca Ferguson, Ryan Reynolds) aboard the International Space Station are on the cutting edge of one of the most important discoveries in human history: the first evidence of extra-terrestrial life on Mars. As members of the crew conduct their research, the rapidly evolving life-form proves far more intelligent and terrifying than anyone could have imagined.
Life was a movie I was curious about. This movie did seem very familiar and similar to other sci-fi horror movies, but because of the very talented cast involved, I was willing to check it out. I have to say, Life actually surprised me quite a bit. It’s nothing really that special and it is quite predictable. However, the film did carry out its story quite well, with its pretty good direction, great acting and actually some scary scenes.
The first act of the movie was rather slow and really didn’t interest me. As soon as the alien starts to attack, that’s when the movie started to really get my attention, that’s when the film really picked up. Most of the movie is fairly predictable, with the exception with something that happens at the end of the first act and the ending of the film, you can just tell what’s going to happen, though a lot of that has to do with the fact that we’ve seen so many of these types of movies, so we can usually tell what direction it’s going in. The film is quite effective with its scares (I’ll go into more detail later on). Overall the execution of this story is what makes this movie work so well.
This movie has a small but talented cast with Jake Gyllenhaal, Rebecca Ferguson, Ryan Reynolds, Hiroyuki Sanada, Ariyon Bakare and Olga Dihovichnaya. The characters they play aren’t really that interesting and due to the writing, there’s not much reason to care about them, aside from the fact that they are characters who are stuck in this situation. But the actors do a great job in their roles despite the lack of development in their characters.
This film is directed by Daniel Espinosa who has directed some movies which I haven’t seen but I’ve heard are ‘okay’ (Safe House, Child 44). I will say that with Life he did a really good job. This film is shot well, the CGI is used quite effectively. Direction-wise, the only issue I had was early in the movie, there is an unnecessary long take shot. These can be quite impressive but it wasn’t really needed at that moment, and it’s not even like the film featured these types of shots throughout, it was a one-off, and wasn’t needed. That’s really it though. This film handles its tension quite well, while the film does have it’s jumpscares, it wasn’t the majority of the scares, and the jumpscares never really felt forced or obnoxious. I found the most effective scares came from the alien itself. The alien itself is quite effective, the way it moved, the way it looked, the movie made it seem like an unstoppable and terrifying force. Plus, we don’t exactly know exactly what it is, the unknown element really helped with the horror.
Life is not one of the greatest sci-fi horror movies out there, it does take a lot from superior sci-fi horror movies like Alien and it is rather predictable throughout. However, if you do like these type of movies, I would recommend that you check out Life. The acting from its talented cast is good, the direction is solid but most of all, this movie is also actually scary, with a very dangerous and threatening antagonist.

Leave a comment